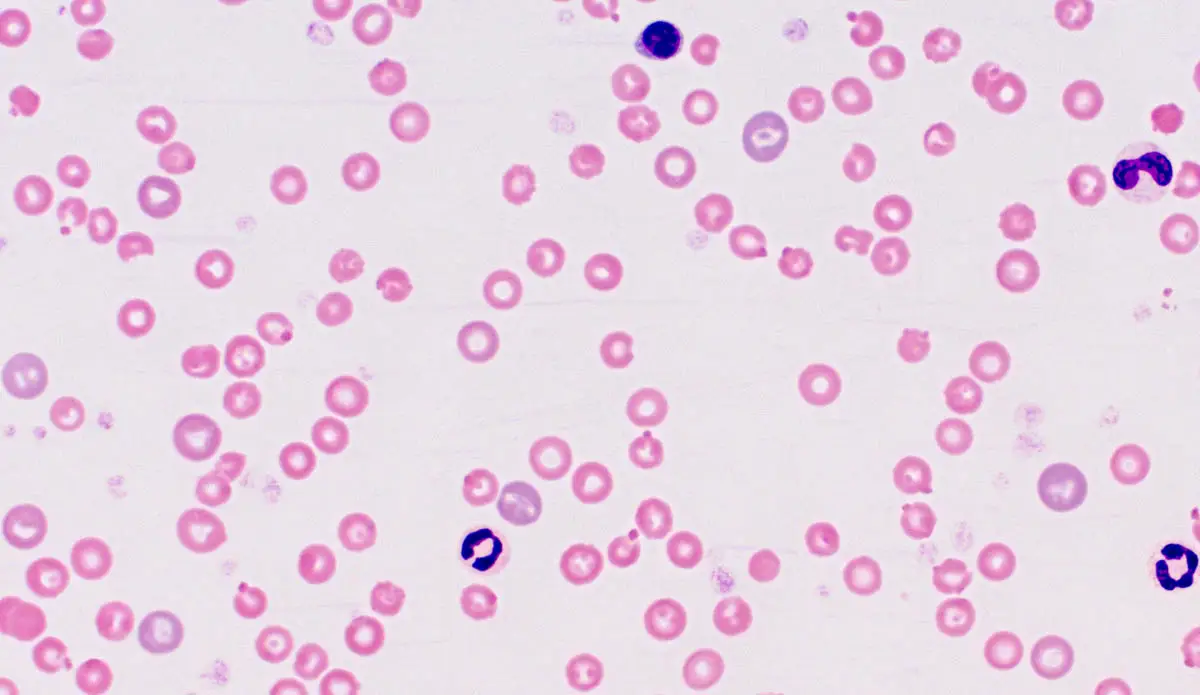

Was ist die Anämie des Heinz -Körpers?
Hinz -Anämie ist eine Anämie (niedrige rote Blutkörperchen, die Sauerstoff übertragen), die HUHz (HB) -Körper in den roten Blutkörperchen haben, die entstehen Emolis ).
Heinz 'Körper entwickelt sich, wenn rote Blutkörperchen oxidativen Faktoren ausgesetzt sind, die Veränderungen verursachen ( Manschette In den roten Blutkörperchen für Hämoglobinketten. Die Bindung (eine Art weiße Blutkörperchen) ist offensichtlich die von der Milz betroffenen roten Blutkörperchen.
Metemoglobinämie ist eine zweite Art von oxidativem Schaden, die im Blut aufgrund des Vorhandenseins von Metlobin (eine abnormale Form von Hämoglobin) auftreten kann. Metemoglobin sollte sich nicht mit Sauerstoff verbinden, was zu einer Verringerung des Vorhandenseins von Sauerstoff in den Geweben führt.
Arten von Anämie:
- Blutverlust
- Nicht reguliert
- Erneuerung
Anämie Blutverlust kann extern (z. B. Wunde) oder innere Blutungen sein.
Nicht reguliert Anämie يرجع إلى انخفاض في إنتاج خلايا الدم الحمراء في نخاع العظم.
Erneuerung Dies tritt auf, wenn die Produktion von roten Blutkörperchen normal ist, aber schneller zerstört wird als es kann.
Anämie do corpo Heinz é uma forma de Anämie rigenerativa Es werden jedoch rote Blutkörperchen produziert, die aufgrund der Bildung von Heinz -Körpern durch das Immunsystem zerstört werden.
OK
Die meisten Fälle von Anämie in Heinz 'Körper sind auf den Verzehr von oxidierten Substanzen wie einigen Medikamenten, Toxinen und Lebensmitteln zurückzuführen, zu denen einige gehören:
- Er sagte, dass Zwiebeln (Zwiebeln, Knoblauch, Knoblauch und Frühlingszwiebeln). Kinderfutter sind Zwiebeln und giftige Knoblauchquellen bei Katzen
- Paracetamol (Barasitamolo)
- Prodeline Glycol (in vielen Produkten, einschließlich Seife, Shampoo, Kindern und einer Vielzahl von konvertierten Lebensmitteln, einschließlich einiger Katzen, halb montiert)
- Venasitin (Wohnung)
- Blaues Methylen (Urinwohnung)
- Benzukayeine (Lokalanästhesie)
- Namanlin (Barty Raws)
- K. -Vitamin
- Zink
Regelmäßige Erkrankungen können auch Heinz -Körper bilden, darunter:
- Arthritis Schwere Komplikationen bei Diabetes, bei denen sich die Ketone und der Blutzuckerspiegel im Körper aufgrund des Insulinspiegels ansammeln, auf den Glukose in die Zellen bewegt werden muss, um Energie zu erreichen. Auf diese Weise verwendet der Körper Fett als alternative Energiequelle, die Ketone erzeugt, die viel saueres Blut erzeugen.
- Hyper
- Lymphom
Klinische Anzeichen
Heinz teste a munkavállaló kitettségétől számított 24 órán belül jelenik meg, de a nyelés és a tünetek megjelenése között több nap késik. A gravitáció az oxidációs fogyasztás mennyiségétől és az expozíció időtartamától függ. Heinz teste általában alacsonyabban termeli őket, mint az étrend és a betegség, mint a gyógyszerek fogyasztása.
- Lethargie
- Disqualifikation
- Bauchschmerzen
- Gelbe Membranen, wenn es einen Feuerwiderstand gibt
- Lineare Linien (Schnelles Atmen)
- Erhöhte Herzfrequenz
- Die Palmmembranen, Rauch und Ciol Marren) sind ein stürmisches Geschenk.
- Hyper
- Schwäche
- Verdauungsstörungen wie Bauchschmerzen, Durchfall und Erbrechen.
In diesem Fall haben wir vor einigen Jahren und die Hauptsymptome der Inaktivität (einen Tag vor der Krankheit), Krüge und Zusammenbruch verloren.
Wenn die Hauptursache die Ursache für systemische Erkrankungen ist, kann es mehrere Symptome geben.
- Diabetes: Der höchste Durst und Urin, Gewichtsverlust, Schwäche der Beine, Früchte.
- Hyper: Increased appetite, weight loss, jittery behaviour, rapid heartbeat.
- Lymphom: Symptoms can vary depending on the location but may include enlarged lymph nodes, anorexia, weight loss, and fever.
Untergang
Der Tierarzt führt eine vollständige körperliche Untersuchung seiner Katze durch und erhält eine medizinische Geschichte, einschließlich der modernen Lebensmittel, die Ihre Katze gegessen hat, Medikamente oder andere Haushaltsprodukte, die Sie erhalten können.
Diagnosearbeit:
- Der Test -basierte : Biochemische Datei zur Bewertung der Funktion der Organfunktion, der Gesamtzahl der Perfektions- und Urinanalyse. CBC kann eine kleine Anzahl von roten Blutkörperchen entdecken und die Ergebnisse können je nach unten abhängiger Grund variieren.
- erlauben Nachweis von Heinz -Körpern in Blutflecken aus Methylenblau. HINWEIS: Katzen können Heinz Körper in blutroten Blutkörperchen ohne Anämie haben.
- Radiologische Bilder im Bauch Finden Sie Mineralien im Falle eines Verdachts der Zinktoxizität.
Wenn die Körper gefunden werden, aber Ihre Katze keinen schlucken Hintergrund (Nahrung, Gift, Medikamente) enthält, hat der Tierarzt die Hauptursache wie systemische Krankheiten. In diesem Fall sind weitere Diagnosen erforderlich.
- Diabetes: Blut- und Urintests auf hohen Glukosespiegel (hoher Blutzucker und Glukose).
- Hyper: Blood tests to check levels of T3 and T4 hormones in the blood.
- Lymphom: Chest and abdominal radiography to look for thickening of the intestines or masses. Biopsy or fine Die aus Geweben und Knochenmark gelernte Nadel kann entfernt werden.
Regieren
Katzen, die mit gefährlicher Anämie zu kämpfen haben, werden ins Krankenhaus gebracht und erhalten Transfusion Hoxchepia.
Vierte therapeutische Flüssigkeit Für Katzen, die gefährlich und/oder Durchfall sind und die Nieren vor der durch Hämoglobin verursachten Läsion schützen.
Die Beobachtung von Konsultationen ist erforderlich, um die Regeneration von roten Blutkörperchen zu bewerten.
Schutz
- Lesen Sie die Aufkleber immer sorgfältig durch und vermeiden Sie Produkte mit Zwiebeln, Knoblauch- oder Allium -Familienmitgliedern.
- Achten Sie darauf, die Pflege zu ignorieren.
- Er behandelte niemals Drogen, es sei denn, der Tierarzt fragte ihn. Katzen sind nicht jung oder Hunde und können nicht viel Medikamente kennenlernen.
- Halten Sie die Produkte mit verbotenem Zink.
- Vermeiden Sie Trick Ball zu Hause.
- Verwenden Sie keine Produkte (z. B. Sonnenschutz), die leicht geleckt werden können.